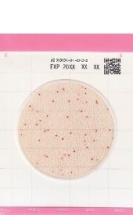
Тест-пластины Easy Plate AC
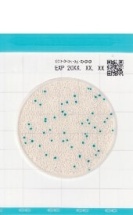
Тест-пластины Easy Plate CC
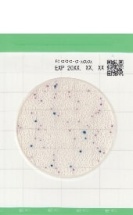
Тест-пластины Easy Plate EC
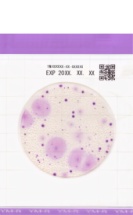
Тест-пластины Easy Plate YMR (экспресс)
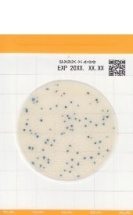
Тест-пластины Easy Plate SA (экспресс)

По популярности (убывание)
По популярности (убывание)
Тест-пластины/Easy Plate
В наличии
Арт. 61973
Тест-пластины для определения количества КМАФАнМ (AC)
Производитель
—
Kikkoman Biochemifa
Микроорганизмы
—
КМАФАнМ
Время инкубации
—
48 ч
Упаковка
—
4 х 25 шт.
Страна производства
—
Япония
Тест-пластины/Easy Plate
В наличии
Арт. 61974
Тест-пластины для определения количества колиформных бактерий (БГКП)
Производитель
—
Kikkoman Biochemifa
Микроорганизмы
—
Колиформные бактерии
Время инкубации
—
24 ч
Упаковка
—
4 х 25 шт.
Страна производства
—
Япония
Тест-пластины/Easy Plate
В наличии
Арт. 61975
Тест-пластины для определения количества E.coli и колиформных бактерий (БГКП)
Производитель
—
Kikkoman Biochemifa
Микроорганизмы
—
E.coli и колиформные бактерии
Время инкубации
—
24 ч
Упаковка
—
4 х 25 шт.
Страна производства
—
Япония
Тест-пластины/Easy Plate
В наличии
Арт. 61977
Тест-пластины для экспресс-определения количества дрожжей и плесеней
Производитель
—
Kikkoman Biochemifa
Микроорганизмы
—
Дрожжи и плесневые грибы
Время инкубации
—
48 ч
Упаковка
—
4 х 25 шт.
Страна производства
—
Япония
Тест-пластины/Easy Plate
В наличии
Арт. 61976
Тест-пластины для экспресс-определения количества стафилококков (Staph. aureus)
Производитель
—
Kikkoman Biochemifa
Микроорганизмы
—
Стафилококки (Staph. aureus)
Время инкубации
—
24 ч
Упаковка
—
4 х 25 шт.
Страна производства
—
Япония